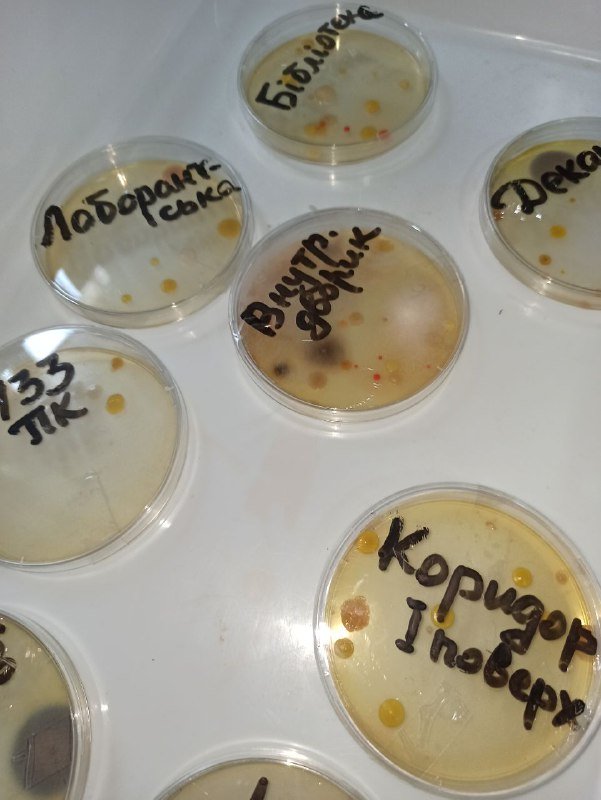
f87d6117-92ce-4a7c-8b80-4ff99672eb50
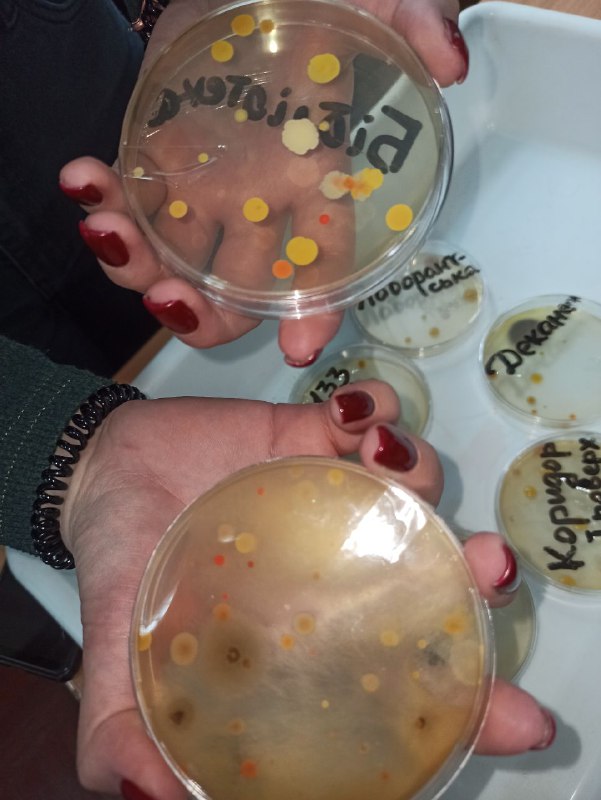
7389bdc8-eec0-4d34-8771-c06e720da654
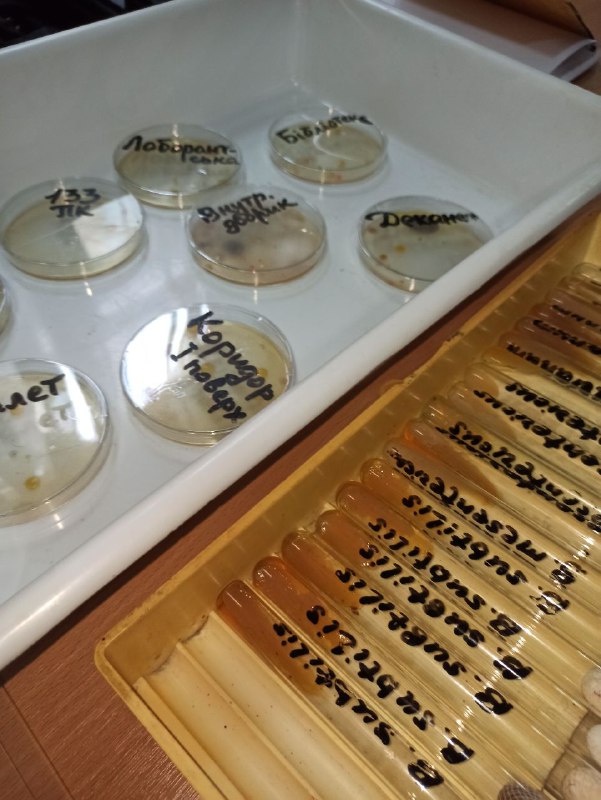
8c91495b-efe3-4b56-b655-7270b35d6ace

Вітання від декана факультету
Шановні студенти та колеги!
Вітання від студентів хіміків з Новим Роком
Вітання від декана факультету
Шановні студенти! Шановні колеги!
Від усього серця вітаю вас із світлим святом Різдва Христового!
Вітання від студентського парламенту факультету
ЄВРОКОМІСІЯ АНОНСУВАЛА НОВІ КОНКУРСИ ЕРАЗМУС+ НА 2024 РІК
28 листопада 2023 року Єврокомісія оголосила про нові конкурси Програми Еразмус+ на 2024 рік — Annual Work Programme 2024. Наступного року Еразмус+ продовжить забезпечувати можливості для обмінів на навчання і практику, стажування й викладання, створення проєктів транскордонного співробітництва у різних сферах . Ввідкрито 35 конкурсів.
Вітання від Test-DAF інституту
Die Adventszeit und das Jahresende sind Zeiten des Innehaltens, des Rückblicks und des Bilanzierens. Ein weiteres Jahr geprägt von großen und kleineren Krisen, aber auch einigen erfolgreichen Aufbrüchen liegt hinter uns. Letztere sind und waren unter anderem das Ergebnis der Zusammenarbeit mit Ihnen. Auch im allgemeinen Krisenmodus des Jahres 2023 gibt es daher viele gute Gründe für Dankbarkeit. Wir danken Ihnen herzlich für Ihr Vertrauen, die Zusammenarbeit und gelegentlich auch Geduld im vergangenen Jahr.
Dem neuen Jahr und der weiteren Zusammenarbeit mit Ihnen blicken wir mit großer Vorfreude entgegen.
Ein glückliches, gesundes und friedvolles Jahr 2024 wünschen Ihnen die Mitarbeiterinnen und Mitarbeiter von g.a.s.t.
Видання підтримують вчених-природознавців
Шановні вчені-природознавці!
У грудні 2023 року українські наукові журнали з природничих наук продовжують об’єднуватися, щоб забезпечувати безперервність вашої наукової діяльності. Саме в єдності – наша сила!
Для вашої зручності було вибрано єдину дату подання матеріалів –
25 грудня, до якої ви можете направити свої статті.
У разі виникнення запитань ви можете звернутися до співробітників видавництва, контакти яких зазначені на сайтах журналів.
Відбувся XX-й конгрес АЕДЕ, на якому в керівний орган цієї організації, бюро АЕДЕ, було обрано президента нашої організації доц. к.п.н. Холоденко Олену Віталіївну.
Щиро вітаємо її з цією подією! Це визнання роботи нашої організації і її президента!
Символічно, що обрання Олени Віталіївни в керівництво АЕДЕ відбулося в той самий день, коли Україна отримала запрошення до початку переговорів щодо вступу України до Європейського Союзу! Тримаємо крок!
Допомога війську
Кафедра іноземних мов природничого факультету Українського державного університету імені Михайла Драгоманова надала допомогу Благодійному Фонду Сергія Гулієва:
Продукти харчування, смаколики, їжа швидкого харчування, теплі шкарпетки
Докладніше >>
У Національному ботанічному саду імені Миколи Гришка на підтримку мужніх воїнів ЗСУ відбулася виставка-ярмарок «Різдвяний вернісаж у Ботанічному саду».
За донат на ЗСУ відвідувачі могли продегустувати та придбати смачну й оригінальну продукцію Відділу акліматизації плодових рослин.
Небайдужі та ініціативні студенти природничого факультету Українського державного університету імені Михайла Драгоманова долучилися до допомоги науковцям у зборі коштів на потреби ЗСУ та мали можливість вивчити та повторити латинські назви нетрадиційних плодових культур, адже всі експонати виставки були підписані науковими ботанічними назвами латиною!
Не залишила байдужими нікого змістовна екскурсія неповторною оранжереєю ботанічного саду, проведена випускницею природничого факультету Іриною Марчук! Тож студенти-біологи неабияк підвищили свою обізнаність в ботаніці та екології рослин.
Дякуємо ЗСУ! Дякуємо усім організаторам благодійного заходу!
Разом до ПЕРЕМОГИ!
До нас завітали випускники 1983 року спеціальностей Географія та Біологія
Спілкування було дуже щирим та приємним. Вони розповіли, що деякі працюють у школах, хтось у наукових установах.
Випускники подивились Біологічний та Геологічний музеї і нові аудиторії. Було приємно вражені змінами на факультеті.
Відділ міжнародних зв’язків інформує
Конкурс для студентів та викладачів на отримання стипендій на навчання та викладання в Мазовецькій академіїї в Плоцьку, Польща (The Mazovian Academy in Płock)в рамках програми ERASMUS +
Український державний університет імені Михайла Драгоманова є партнером Мазовецької академії в Плоцьку в рамках проєкту КА171 Міжнародна мобільність (програми Еразмус + , що фінансується ЄС).
Слава Героям України!
Дорогі захисники і захисниці Велика Вам подяка, Ангела Охоронця Вам усім та Божої ласки!
ВІЙСЬКОВА ПІДГОТОВКА
КАФЕДРА ВІЙСЬКОВОЇ ПІДГОТОВКИ НАЦІОНАЛЬНОГО УНІВЕРСИТЕТУ ОБОРОНИ УКРАЇНИ ІМЕНІ ІВАНА ЧЕРНЯХОВСЬКОГО ЗАПРОШУЄ ГРОМАДЯН УКРАЇНИ ОТРИМАТИ ВІЙСЬКОВУ ПІДГОТОВКУ ЗА ПРОГРАМОЮ ОФІЦЕРІВ ЗАПАСУ!
Готуємось до Різдва
Студенти нашого факультету відвідали етнографічний центр «Цінності», де отримали можливість навчитися робити свічки із воску. Виготовленню свічок відводилося значне місце в традиційно-побутовій культурі українців. Вважалося, що робити їх можуть лише люди старшого віку. Особливого значення надавали богоявленській, громничий, страсній та свічкі-трійці. Вони є оберегами від всього злого та нечистого.







Он-лайн курс підвищення кваліфікації
Шановні колеги!
За підтримки австрійської організації OЕAD у листопаді та грудні 2023 року на безоплатній основі відбуватимуться цікаві та змістовні вебінари для вчителів біології, хімії, англійської мови та інших дисциплін. Зареєстрованим учасникам надається доступ до матеріалів попередніх вебінарів.
Зареєструватися на вебінари можна, заповнивши цю Гугл-форму:
Міжнародна науково-практична онлайн-конференція
Міжнародна науково-практична онлайн-конференція:
«НАВЧАННЯ І ВИКЛАДАННЯ У БАГАТОМОВНОМУ СВІТІ”
1-2 грудня 2023 року м. Київ, Україна
З темою «НАВЧАННЯ І ВИКЛАДАННЯ У БАГАТОМОВНОМУ СВІТІ” , лекторки ДААД Аня Ланґе (Бішкек) і Катрін К. Компе (Алмати), ДААД-лектор Мікелє Ванджі (Київ), експертка з організації навчального процесу з Гете-Інституту Керстін Далльйо (Київ), за дружньої підтримки ГО «Європейська освіта і наука в Україні» і «Української спілки германістів вищої школи”, запрошуємо до участі викладачів університетів, аспірантів і зацікавлених студентів у міждисциплінарній конференції в режимі онлайн.
Захід відкритий для учасників з усіх галузей знань.
Мови конференції: німецька і українська.
1 та 2 грудня кафедрою Іноземних мов Природничого факультету була проведена міжнародна конференція
«Навчання і викладання у багатомовному світі у цифровому форматі».





Всеукраїнська науково-практична конференція
Шановні колеги !
29 листопада 2023 року запрошуємо науковців, науково-педагогічних працівників, викладачів навчальних закладів, аспірантів, магістрів, студентів, інженерно-технічних працівників та всіх зацікавлених осіб до участі у VІІI Всеукраїнській науково-практичній конференції «Енергоефективність: наука, технології, застосування»
Щорічний конкурс
на краще видання, яке отримало визнання серед наукової та освітянської спільноти (за період з 2021 по 2023 роки)
Термін подання робіт - до 30.11.2023 року
ВІТАЄМО
з нагородами!
Благодійний ярмарок
13 листопада відбувся благодійний ярмарок "Серце листопада"🍂
🤗Природничий факультет, разом з Факультетом спеціальної та інклюзивної освіти підготували різні смаколики, вироби ручної праці та різні локації (хімічні досліди, фотозону), картини, солодощі, печиво та навіть українську кухню.
Всі кошти будуть передані студентам нашого університету, які проходять в службу в лавах ЗСУ, або потребують підтримку після наслідків війни!
Міжнародна наукова конференція
10 листопада 2023 р.
III Міжнародна наукова конференція
«Інновації та науковий потенціал світу»
До участі запрошуються науковці, викладачі, аспіранти, а також студенти з науковими керівниками.
До публікації приймаються як тези (2-5 сторінок), так і статті (6-12 сторінок, з анотацією).
Підвищення кваліфікації
Відбувся Науковий вебінар
02 листопада 2023 року о 14.30 на платформі Zoom згідно з планом заходів Школи академічної доброчесності природничого факультету на 2023-2024 н.р. було проведено науковий вебінар на тему:
«Дотримання академічної доброчесності у процесі написання магістерської роботи: необхідність уникати плагіату».
На вебінарі були присутніми понад 60 учасників - магістранти денної та заочної форм навчання природничого факультету, наукові керівники кваліфікаційних робіт та завідувачі кафедр.
Науковий вебінар
02 листопада 2023 р. о 14:30
відбудеться Науковий вебінар
Тема : «Дотримання академічної доброчесності у процесі написання магістерської роботи: необхідність уникати плагіату»
Для кого? Магістри денної та заочної форм навчання Природничого факультету, наукові керівники магістерських робіт
https://us04web.zoom.us/j/76283849704?pwd=asSg8nYeG0anBBqB08pOepb2s3h6m6.1
Історія України в архітектурі
27 жовтня студенти Природничого факультету відвідали історико-культурний заповідник «Качанівка», який був створений у 1971 році на основі палацового ансамблю та парку дворянської садиби, заснованої в 1770-з х роках , яка на сьогодні є єдиною серед українських садиб, що збереглася до наших днів.
Багато видатних митців 19 століття знаходили творче натхнення, перебуваючи в Качанівка: Т.Шевченко, М. Котомаров, М. Гоголь, М. Глинам, Д. Яворницький, І. Регін, М. Щепкін. Студенти подивились парк та внутрішні кімнати будинку.








ОГОЛОШЕННЯ
25 жовтня 2023 року о 12.00 у 305 аудиторії
відбудуться загальні збори органу громадського самоврядування природничого факультету
УДУ імені Михайла Драгоманова.
Засідання відбудеться в ОЧНОМУ форматі.
Порядок денний:
- Конкурсні справи: про рекомендацію кандидатур на посади завідувачів кафедр біології, географії, методики навчання природничих дисциплін та туризму.
Присутність усіх членів трудового колективу обов’язкова.
Видання підтримують вчених-педагогів
Шановні вчені-педагоги!
Наші науковці з перших днів війни згуртувалися та забезпечили безперервність наукової діяльності і своєчасний випуск номерів журналів із педагогічних наук попри всі жахіття війни.
Коли наукові журнали інформували про підтримку вчених-педагогів у березні, ми всі сподівалися, що незабаром в Україну повернуться мир і безпечне життя. Оскільки цього, на жаль, на цей час ще не сталося, ми продовжуємо підтримувати вчених-педагогів до кінця 2023 року.
Для вашої зручності було вибрано єдину дату подання матеріалів – 31 жовтня, до якої ви можете направити свої статті.
19 жовтня 2023 року в центральному корпусі драгоманівського університету відбувся науково-пізнавальний захід
«Цікава наука Science is Fun».
Організатори продемонстрували цікаві досліди в області хімії, біології, фізики, астрономії, розкрили таємниці інформатики та конструювання робототехніки.
Студенти природничого факультету і факультету математики, інформатики та фізики довели, що наука цікава, доступна для кожного, корисна і потрібна суспільству.



По той бік миру
18 жовтня студенти та викладачі нашого університету зустрілись із знімальною групою документальних фільмів
«По той бік миру» та «Мистецтво проти війни».
Режисер цих фільмів Олексій Дмитрашківський розказав про те, як знімались ці фільми, про людей з Бучі, Ірпеня, Гостомелю, які пережили окупацію російських фашистів, вистояли і залишились патріотами рідної України.
Традиції України, які треба плекати
Нещодавно студенти нашого факультету відвідали етнографічний центр «Цінності», де познайомились із українським вбранням з різних регіонів.
Унікальні приклади національного строю 19-21 сторіччя та можливість приміряти їх , а також історії та традиції весільного обряду дуже вразили студентів. Вивчення народних танців, які були популярні у минули сторіччя, викликали велике задоволення та зацікавленість.









Підвищення кваліфікації
Студенти вітають викладачів з Днем працівників освіти!
Вітаємо!
Валентину Сергіївну Толмачову
завідувачку кафедри хімії
з нагородою: Медаллю "Хрест Свободи"
За жертвенне служіння задля збереження Божого дару свободи та незалежності
від Митрополіта Київського та всієї України, † Епіфанія
Вітаємо!
Бикову Марію Дмитрівну
доцента кафедри туризму
з нагородою: Грамотою НАПН України
За вагомий внесок у підготовку висококваліфікованих спеціалістів, плідну науково-педагогічну діяльність та з нагоди Дня працівників освіти України
Шановні абітурієнти!
з 2 по 21 вересня
Друга сесія подання заяв та документів для вступу на бакалаврат, магістратуру, другу вищу освіту через електронні кабінети вступника (тільки на контракт)
Міжнародна наукова конференція
Запрошуємо до участі в міжнародній науковій конференції на тему:
Multidisciplinary challenges in contemporary science: innovations and collaboration
Мова написання наукових тез: українська та англійська.
Форма проведення конференції: дистанційна (тільки публікація тез).
Країна проведення: Польща
Дата проведення: 15 вересня 2023 року
Тези для конференції приймаються до 5 вересня включно
Вітаємо
колектив природничого факультету
з отриманням
2 місця
серед усіх факультетів нашого університету
у номінації
"Факультет у 2022-2023 навчальному році"
Вітаємо
завідувача кафедри методики навчання природничих дисциплін природничого факультету,
доктора педагогічних наук, професора,
КОБЕРНІКА СЕРГІЯ ГЕОРГІЙОВИЧА
з 1 місцем
в нашому університеті за результатами конкурсу в номінації
"Професор 2022-2023 навчального року"
Бажаємо Вам творчого надхнення !
Молитва в Софії Київській під час війни
Господи Ісусе Христе, Боже наш,
Молюся до Тебе в храмі Премудрості, тисячолітній Софії Київській,
перед іконою Пречистої Матері Твоєї «Непорушна стіна», що є берегинею Києва і народу нашого.
Не лише на зброю нашу надію покладаємо, а й на Тебе, Всемогутнього Бога.
Подай же Україні нашій, Європі і всьому світові справжній мир, мудрість і силу зупинити зло і війну.
Упокой усіх захисників і захисниць країни і народу нашого,
та всіх мирних жителів, що загинули, – дітей, жінок і чоловіків, ім’я кожного з яких Ти знаєш, – і прийми їх в оселі праведних.
Вилікуй поранених і травмованих фізично і морально.
Утіш тих, хто втратив рідних і близьких.
Заспокой тих, хто наляканий та розгублений.
Збережи тих, хто під обстрілами, в полоні й небезпеці.
Дай сили і мужність боголюбивому народу нашому, владі і війську, що захищають нас,
і допоможи їм звільнити нашу країну від підступного і безжалісного ворога.
І дай нам в мирі благословляти і прославляти Тебе.
Бо Ти є Бог наш, Володар миру і світу, Спаситель душ наших, і Тобі славу возсилаємо нині, і повсякчас, і на вікі віків.
Амінь.
Боже Великий Єдиний, нам Україну храни!
Курс для студентів біологічного профілю
УВАГА!
Реєстрація на курс відбувається до
5 вересня 2023 р.
Шановні абітурієнти!
Для зарахування на контракт (магістратура)
з 24 серпня по 04 вересня (включно, до 18.00)
Ви повинні підтвердити у власному електронному кабінеті вступника рекомендацію на контракт власним електронним підписом. Якщо, потрібна допомога, звертайтеся у приймальну комісію до технічних секретарів.
1 вересня - День знань!
Шановні студенти, викладачі, батьки!
Щиро вітаю вас із святом 1 вересня. І хоча нам усім зараз вкрай непросто, ми знаємо, що Україна вистоїть у боротьбі із підступним ворогом. Саме сьогодні починається дорога в майбутнє для кожного студента.
Ми дуже раді бачити вас у лавах нашого університету. День знань є всенародним святом душевності, мудрості та людяності. Він особисто урочистий і хвилюючий, адже саме з нього починається цікавий, незвіданий, і, водночас, нелегкий шлях до пізнання, до нових звершень, до самостійного життя.
Бажаю усім студентам підкорити нові вершини знань, зустріти добрих і надійних друзів та досягти омріяної мети. Хочу подякувати усім викладачам за вашу натхненну працю, великі серця і знання, якими ви ділитесь із студентами.
Хай цей навчальний рік стане перемогою кожного особисто та усієї нашої країни.
Із святом!!!!!! Бажаю усім успіхів !!!!!!
Ваш декан
Міжнародна науково-практична конференція
Шановні колеги!
Запрошуємо Вас взяти участь у Міжнародній науково-практичній конференції “Стан, проблеми та перспективи розвитку науки, освіти і технологій”, яка відбудеться 29 серпня 2023 року року в м. Кременчук, Україна
Національна платформа можливостей професійного
розвитку педагогічних працівників «EdWay»
Шановні абітурієнти!
Для зарахування на бюджет (магістратура)
з 24 по 29 серпня (включно, до 18.00)
Ви повинні підтвердити у власному електронному кабінеті вступника рекомендацію на бюджет власним електронним підписом. Якщо, потрібна допомога, звертайтеся у приймальну комісію до технічних секретарів.
З Днем Незалежності!
День Незалежності у 2023 році українці, вже другий рік поспіль зустрічають у боротьбі з російськими загарбниками, протистоячи військам окупантів, відстоюючи права і свободу, захищаючи гідність, честь, життя і незалежність - своїх дітей та своєї країни.
Неважливо, де ми народилися: в Києві чи Маріуполі, Львові чи Донецьку, Полтаві чи Миколаєві, тільки одне має вирішальне значення: наша спільна Батьківщина і наше спільне майбутнє. Разом ми усе зможемо!
З Днем Державного прапора!
В усьому світі синьо-жовтий колір нашого стяга уособлює сміливість, незалежність, демократичні цінності й найкращі чесноти, властиві мужньому українському народові.
І це, звичайно, ж колір нашої перемоги, яку впевнено наближають наші Збройні Сили України, усі українці на фронті і в тилу. Перемога неодмінно буде за Україною!
З Днем Державного прапора!💙💛
Виставка робіт Остапчук Анастасії
Остапчук Анастасія
Випускниця 4 курсу природничого факультету. Має диплом з відзнакою, вступає до нас на магістратуру. Захоплюється не тільки біологією, але і малюванням. Працює у школі, дуже любить дітей, тому саме ілюстрації дитячі. Її сестра навчається на 2 курсі нашого факультету, на кафедрі біології. Тому любов до нашого вузу у них сімейне!
Дуже щасливі, що Ви дозволили зробити цю виставку і дали можливість працівникам університету та студентам побачити роботи Насті!








Шановні абітурієнти!
Для зарахування на бюджет (бакалаврат)
з 4 по 8 серпня (включно)
Ви повинні підтвердити у власному електронному кабінеті вступника рекомендацію на бюджет власним електронним підписом. Якщо, потрібна допомога, звертайтеся у приймальну комісію до технічних секретарів.
Науково-педагогічне стажування
Науково-педагогічне стажування
«Традиційні та інноваційні підходи до підготовки педагогів та психологів у ЗВО України та країн ЄС»
м. Рига, Латвійська Республіка
3 липня – 13 серпня 2023 року
Шановні абітурієнти! Фахові вступні іспити в магістратуру 18.07. (10:00)
Реєстрація на фахові вступні іспити проводиться у власних електронних кабінетах з 1 по 16 липня (до 18:00).
Приклад реєстрації електронного кабінету на фаховий іспит
https://t.me/chemistry_fpgoe/45
РОЗКЛАД
фахових вступних іспитів
для вступу до УДУ імені Михайла Драгоманова у 2023 році
для здобуття ступеня МАГІСТРА на основі НРК6/НРК7 (бакалавр/магістр)
(на місця державного замовлення та/або на місця за кошти фізичних осіб)
Фахові вступні іспити
для вступу до УДУ імені Михайла Драгоманова у 2023 році проводяться дистанційно.
Реєстрація на фахові вступні іспити (для абітурієнтів з дипломами після 2000 року випуску) проводиться в їх електронних кабінетах з 1 по 16 липня (до 18:00).
Шановні абітурієнти!
з 31 липня по 21 серпня
Подання заяв та документів для вступу в магістратуру через електронні кабінети вступника.
Реєстрація на фаховий іспит, для тих, хто не пройшов його в нашому університеті - до 9 серпня.
Основні терміни вступної кампанії
Вітаємо з нагородою!
Вітаємо доктора біологічних наук, професора, завідувача кафедри екології
Волошину Наталію Олексіївну
з нагородою за активну життєву позицію при реалізації національної екологічної політики,
успіхи в природоохоронній діяльності
та підготовці висококваліфікованих фахівців екологів!
Бажаємо успіхів і натхнення!
Відвідини музеїв природничого факультету
22.06.2023 року на природничий факультет Українського державного університету імені Михайла Драгоманова завітали головний геолог групи компаній Ferrexpo, Олександр Білоус; головний геолог ТОВ «Єристівський гірничо-збагачувальний комбінат» Олексій Ніколаєв та геолог цього підприємства і аспірант Державної наукової установи «Центр проблем морської геології, геоекології та осадового рудоутворення НАН України» Марк Саакян.
Гості ознайомилися з наявними експонатами та пообіцяли допомогу у їх поповненні.
Такі зустрічі і співпраця виробничників і освітян є запорукою співпраці з покращення освітнього процесу та підготовки висококваліфікованих фахівців.
Повідомляємо вам про запуск нашого нового навчального курсу
"Активна молодь — рушій розвитку громад".
Цей курс спрямований на те, щоб надати молоді інструменти та знання, які допоможуть активно взаємодіяти з громадою, місцевим самоврядуванням та вносити позитивні зміни у розвиток країни.
Перша лекція, яка відбудеться 13 червня, розпочнеться тестуванням знань.
Проєкт реалізується ГО "Фонд сприяння демократії" в рамках грантового конкурсу «Голоси громад в умовах війни», що впроваджується НУО «Сучасний Формат» за підтримки Національного фонду сприяння демократії.
Партнер проєкту — Молодь Львівщини (Управління молоді та спорту Львівської обласної державної адміністрації).
Учені-педагоги! Тримаємось та тримаємо!
Шановні вчені-педагоги!
Ми з вами вдруге зустрічаємо наше літо під час війни. Ми навчилися жити та розвиватися в умовах війни, дбаючи про своїх близьких та створюючи безпечні умови для щасливого дитинства наших дітей.
У червні 2023 року українські наукові журнали з педагогічних наук продовжують об’єднуватися, забезпечувати безперервність Вашої наукової діяльності. Саме в єдності – наша сила!
Для вашої зручності було вибрано єдину дату подання матеріалів – 27 червня, до якої ви можете направити свої статті.
У разі виникнення запитань ви можете звернутися до співробітників видавництва, контакти яких зазначені на сайтах журналів. Ми на зв’язку!
😥 Драгоманівський університет зазнав тяжкої втрати: на війні загинув випускник кафедри туризму 2017 р.,
Руслан Шеремет.
Хоробрий патріот, романтик, скромний та вірний шляху воїна-розвідника українець. Ніколи не забудемо Героя, який без вагань віддав найцінніше - своє життя - за свій народ, свою країну.
Герої житимуть вічно в пам'яті вдячного народу.
Важко знайти слова втіхи й підтримки для рідних, друзів полеглого воїна. Це непоправна втрата, з приводу якої співчувають близьким колектив кафедри, факультету та університету.
🕯🙏 Вічна Пам'ять і Слава!
Допомога родині нашого воїна
Для тих хто хоче допомогти родині Руслана:
5167 8032 8973 1502 - батько Руслана
Не будьмо байдужими до біди, яка спіткала родину нашого воїна!
Вітаємо
доктора філологічних наук, професора кафедри іноземних мов природничого факультету
Світлану Мар'янівну Іваненко
з нагородженням Ювілейною медаллю імені Михайла Драгоманова!
VI Міжнародна конференція молодих учених
ХАРКІВСЬКИЙ ПРИРОДНИЧИЙ ФОРУМ
19-20 травня 2023 р.
До участі у конференції запрошуються студенти, аспіранти та молоді науковці. Для цього необхідно до 5 травня 2023 року надіслати заявку та тези на Гугл диск відповідно до секції, а також на електронну адресу: [email protected]
Щиро вітаємо!
17 травня 2023 року відбулися
загальні збори трудового колективу природничого факультету УДУ імені Михайла Драгоманова.
Рішенням зборів органу громадського самоврядування природничого факультету Українського державного університету імені Михайла Драгоманова погоджено рекомендовану конкурсною комісією університету кандидатуру заслуженого працівника освіти України, кандидата педагогічних наук, доцента Турчинової Ганни Володимирівни на заміщення вакантної посади декана природничого факультету.
Шановна, Ганно Володимирівно!
Щиро вітаємо Вас та бажаємо міцного здоров’я, успіхів у реалізації творчих ідей та нових звершень на освітянській ниві.
Оголошення
17 травня 2023 року о 14 год. у 418 аудиторії відбудуться
загальні збори трудового колективу природничого факультету УДУ імені Михайла Драгоманова
Засідання відбудеться у ОЧНОМУ форматі.
Присутність усіх членів трудового колективу обов’язкова!
Порядок денний:
- Про погодження рекомендованої конкурсною комісією Українського державного університету імені Михайла Драгоманова кандидатури заслуженого працівника освіти України, кандидата педагогічних наук, доцента Турчинової Ганни Володимирівни на заміщення вакантної посади декана природничого факультету.
Голова органу громадського самоврядування
природничого факультету доц. А.В. Кустовська
У місті Бухарест (Румунія) відбувся Конгрес Європейської Асоціації Вчителів (AEDE) присвячений обговоренню питань якості Європейської освіти.
На Конгресі були присутні викладачі кафедри іноземних мов Природничого факультету УДУ імені Михайла Драгоманова кандидат педагогічних наук, доцент Холоденко О.В. та кандидат педагогічних наук, доцент Смольнікова О.Г.
Учасницями була представлена інформація про особливості організації освітнього процесу в Україні в умовах військової агресії.
Також з великою увагою були заслухані інші доповідачі, більшість з яких говорили про необхідність комп’ютеризації освітнього процесу, впровадження космічних досліджень в освітній процес, значення цифрової освіти і цифрової гігієни, розвитку ключових компетенцій та формування Європейських цінностей в освітньому середовищі.
Міжнародна наукова конференція
Вельмишановні колеги!
Запрошуємо Вас взяти участь у ХVI Міжнародній науковій конференції
«Актуальні проблеми романо-германської філології та прикладної лінгвістики»,
яка відбудеться
12 травня 2023 року
у Чернівецькому національному університеті імені Юрія Федьковича.
Науково-педагогічне підвищення кваліфікації
До участі у всеукраїнському науково-педагогічному підвищенні кваліфікації
запрошуються науково-педагогічні співробітники закладів вищої освіти, наукові співробітники наукових установ, практичні працівники, докторанти, аспіранти, студенти та всі охочі, які зацікавлені запропонованою тематикою.
Кіноклуб "Екодискурс"
На природничому факультеті започатковано роботу кіноклубу "Екодискурс" завдяки ініціативі Австрійського культурного форуму, з яким у факультету давні дружні відносини. Нагодою слугували Дні австрійського кіно в Україні, які проводяться під патронатом Австрійського культурного форму і Посольства Австрії в Україні.
Тиждень австрійського кіно промайнув дуже швидко, а хотілося, щоб більше молодих людей подивились якісне кіно з Австрії. Тепер у нас є для цього кіноклуб "Екодискурс".
Перший фільм, який переглянули наші студенти 25 квітня - це кінокомедія "Ризики і побічні ефекти", а 27 квітня демонструвався фільм "Францові історії". Це також кінокомедія, знята за оповіданнями відомої австрійської письменниці творів для дітей і юнацтва Крістіни Ньостлінгер.
До нових переглядів!
Демонстрація кінофільму з Австрії
Кафедра іноземних мов природничого факультету
запрошує студентів та викладачів
відвідати демонстрацію кінофільму “Францові історії” (кінокомедія)
з Австрії, озвучену українською мовою
27 квітня 14:00 в аудиторії 401.
Попередньо ви можете ознайомитися з трейлером фільму: https://youtu.be/PrBiQ-SoLZQ
Інформація про фільм: https://kinoklub.org.ua/ua/films/geschichten-vom-franz/#
Сайт кіноклубу: https://kinoklub.org.ua/
Зверніть увагу, захід відбуватиметься оффлайн, тобто наживо, безпосередньо в аудиторії. Онлайн трансляції не буде. Приходьте, долучайтеся, проводьте час приємно та з користю!
На Природничому факультеті Українського державного університету імені Михайла Драгоманова проведено День відкритих дверей
Ми відкриваємо двері назустріч вашому бажанню вивчати
біологію, географію, хімію, екологію та туризм!
25 квітня проведено презентацію нашого факультету, з якою Ви можете ознайомитися за посиланням: https://drive.google.com/file/d/1rq8ulz_1-grxS5qSfD__gkMGEtoiCCso/view?usp=share_link
Ви дізнаєтесь:
чим займаються та чого прагнуть викладачі та студенти природничого факультету
познайомитеся з деканом факультету Ганною Володимирівною Турчиновою та завідувачами кафедр
почуєте про умови вступу та переваги навчального процесу на природничому факультеті.
Вітаємо
студента ІІ курсу спеціальності 014.05 Середня освіта (Біологія та здоров'я людини)
Бухомета Михайла Владиславовича
з врученням
Грамоти за високий професіоналізм, успішне проведення теоретичних та практичних навчань з військової підготовки військовослужбовців Збройних Сил України для захисту незалежності, суверенітету і територіальної цілісності України.

Пишаємося здобутками наших студентів!
25 квітня 11:00 День відкритих дверей Природничого факультету
Природничий факультет Українського державного університету імені Михайла Драгоманова запрошує вас на День відкритих дверей 


Ми відкриваємо двері назустріч вашому бажанню вивчати біологію, географію, хімію, екологію та туризм!
Ми проведемо презентацію нашого факультету, а ви зможете познайомитися та поспілкуватися з нашими студентами та викладачами
Тож знайдіть годинку часу для того, щоб дізнатися про факультет своєї мрії. Та заповни цю гугл-форму, щоб ми могли тобі нагадати листом на вказану електронну пошту про нашу зустріч, щоб її не проґавити: https://docs.google.com/forms/d/1wI4A59W6SY5zGgo6bjHSZDirHt3_dbfw-f-rGBJhMQs/edit
Під час Дня відкритих дверей ви:
дізнаєтесь, чим займаються та чого прагнуть викладачі та студенти природничого факультету
познайомитеся з деканом факультету Ганною Володимирівною Турчиновою та завідувачами кафедр
і звичайно почуєте про умови вступу та переваги навчального процесу на природничому
Отже, 25 квітня, 11:00, online в Zoom за посиланням: https://us02web.zoom.us/j/89698216461?pwd=aERLbTR3QTFtQ280d2JZdmlnUzNlZz09
Натискайте "Цікавить" та долучайтеся - поспілкуємося, все покажемо, все розкажемо. Будемо раді бачити вас!
До події на фб можна долучитися ось тут: https://facebook.com/events/s/день-відкритих-двереи-природни/984872232951220/
Кафедра іноземних мов природничого факультету
запрошує студентів та викладачів
відвідати демонстрацію кінофільму “Ризики та побічні ефекти” (кінокомедія)
з Австрії з субтитрами англійською та українською мовами
25 квітня 14:00 в аудиторії 402.
Зверніть увагу, захід відбуватиметься оффлайн, тобто наживо, безпосередньо в аудиторії. Онлайн трансляції не буде. Приходьте, долучайтеся, проводьте час приємно та з користю!
Вебінар
Не пропустіть шанс дізнатися про найкращі закордонні практики онлайн-освіти від глобальної організації із забезпечення якості Quality Matters (QM).
QM — це понад 1000 проведених досліджень онлайн-навчання, стотисячна спільнота найуспішніших у цій сфері закладів освіти з США та інших країн, найкращі експерти та досвід.
24 квітня о 16:00 фахівці QM спільно з Національним агентством проведуть вебінар «Забезпечення якості онлайн-освіти», де обговорюватимуться питання студентоцентрованого навчання, підвищення мотивації, забезпечення результативності та методи оцінювання в умовах навчання онлайн.
Реєструйтесь та залишайте свої запитання до спікерів за посиланням: bit.ly/41bXZ6T
Вітаємо!
На засіданні Вченої ради Природничого факультету були вручені
Почесна грамота УДУ імені Михайла Драгоманова доценту кафедри біології Настеці Тетяні Миколаївні та Грамоти УДУ імені Михайла Драгоманова доценту кафедри біології Лагутенко Оксані Тарасівні та доценту кафедри іноземних мов природничих факультетів Смольніковій Олені Геннадіївні за багаторічну сумлінну працю та з нагоди ювілейних дат.
Нагороди вручила декан факультету Турчинова Ганна Володимирівна.
Вітаємо колег! Бажаємо міцного здоров'я та нових здобутків!



Вітаємо!
Вітаємо студентів нашого факультету
Руденко Іванну,
Барабаш Богдану та
Карпенко Єлизавету,
які стали переможцями фестивалю Фart 2023.
Шановні студенти, колеги!
У четвер 20 квітня о 12.30 відбудеться відкрита лекція фахівця з ДУ ІГЗ імені О.М. Марзєєва на тему:
"Принципи організації харчування в дитячих освітніх закладах".
Лектор Станкевич Тетяна Валеріївна, канд.мед.наук, провідний науковий співробітник лабораторії соціальних детермінант здоров'я дітей ДУ "Інститут громадського здоров’я ім О.М.Марзєєва Національної академії медичних наук України".
Вітаємо з Великоднем!
Щирі вітання із пасхальними святами!
Нехай у дні світлого Великодня будуть почуті усі добросердечні молитви. Миру, здоров’я і Божої благодаті вам та вашим близьким.
Терпіння, поваги і любові у кожну домівку, а також незламної віри, що ніколи не полишить ваші серця.
З Великоднем, зі світлим Христовим Воскресінням!
Тиждень студентської науки
5 квітня 2023 року в рамках тижня студентської науки на запрошення кафедри біології перед широкою аудиторією студентів та викладачів Природничого факультету УДУ імені Михайла Драгоманова
виступив науковий співробітник Інституту гідробіології НАН України, кандидат біологічних наук Микола Володимирович Причепа
з лекцією на тему: "Водяні рослини як біотопічна складова для існування риб та водно-болотних птахів".
Посилання на гугл-форму із завданнями олімпіади:
Тиждень студентської науки
04 квітня 2023 року на природничому факультеті відбулося пленарне засідання щорічної звітно-наукової конференції студентів та аспірантів
«Освіта і наука - 2023».
У роботі конференції взяли участь понад 80 студентів, завідувачі кафедр та викладачі. Під час конференції учасники обговорили актуальні концепти сучасних наукових досліджень в галузі природничих наук, педагогіки та туризму і рекреації.
Пленарне засідання звітно-наукової конференції студентів і аспірантів
"Освіта і наука – 2023"
Вівторок, 4 квітня · 14:00 – 16:00
Інформація для приєднання до зустрічі Google Meet
Посилання на відеодзвінок: https://meet.google.com/xrg-pnxy-arq
ВІТАЄМО З ДНЕМ НАРОДЖЕННЯ ДЕКАНА НАШОГО ФАКУЛЬТЕТУ!!!
Ганна Володимирівна,
Бажаємо Вам Сонячних днів! Миру, Тепла і Добра!
Віри, Надії, Сили та Перемоги!
Найкращі вітання з Днем народження!
З повагою, викладачі, співробітники і студенти факультету
Звіт семінар-дебати
30 березня 2023 р. о 14:00 - 15:30 відбувся Семінар-дебати для студентів IV курсу денної та заочної форм навчання природничого факультету, наукових керівників бакалаврських робіт
на тему: «Бакалаврська робота без плагіату: чи можливо уникнути запозичень у змісті студентських наукових досліджень?»
Семінар-дебати для студентів IV курсу денної та заочної форм навчання природничого факультету, наукових керівників бакалаврських робіт
на тему: «Бакалаврська робота без плагіату: чи можливо уникнути запозичень у змісті студентських наукових досліджень?»
Форма проведення: онлайн вебінар в Zoom.
Дата: 30 березня 2023 р. Час: 14:00 - 15:30 Посилання на зустріч
Шановні вчені-педагоги!
Ми з вами зараз перебуваємо на важкому шляху до Перемоги, зустрічаючи вже другу весну під час війни. Наша єдність та віра у світле майбутнє допоможуть досягти спільної мети.
У березні 2023 року українські наукові журнали з педагогічних наук продовжують об’єднуватися, забезпечувати безперервність вашої наукової діяльності.
Саме в єдності – наша сила! Для вашої зручності було вибрано єдину дату подання матеріалів – 31 березня.
Вітаємо Жукову Дар‘ю, студентку нашого факультету, з обранням
Головою Студентського парламенту університету!
Бажаємо Жуковій Дар‘ї та її команді плідної роботи
та реалізації планів і ідей!
ВЕБІНАР
Федерація роботодавців України спільно з Освітнім центром економіки землі Мекленбург-Передня Померанія продовжує серію вебінарів за напрямком
«Професійне навчання та розвиток людського капіталу»
і запрошує Вас 17.03.2023 об 11.00 на міжнародний вебінар
«Відповідність сучасної вищої освіти вимогам ринку праці – важливість професійно-кваліфікаційних вимог»
Science is fun 13.03.2023

Вітаємо Бикову Марію Дмитріївну, кандидата географічних наук, з отриманням диплому доцента!
Короткострокові онлайн-курси від EU4Skills
Шановні колеги!
20 лютого 2023 року відкрили доступ до нових короткострокових онлайн-курсів від EU4Skills. Звертаємо вашу увагу на наявність курсу під назвою
"Перша домедична допомога".
Нові навички можуть набути не тільки студенти та педагоги, а й усі бажаючі.
Доступ до курсів можна знайти за посиланням: http://bit.ly/3InUnqB
Центр культури та мистецтв Українського державного університету імені Михайла Драгоманова
оголошує початок прийому заявок
на Третій дистанційний міжуніверситетський фестиваль-конкурс аматорського мистецтва Фart 2023.
Запрошуємо до участі у трьох номінаціях
"Вокал", "Хореографія", "Художнє читання"
студентів, викладачів, співробітників вищих навчальних закладів освіти України!
Наша творчість - то теж зброя!
Зброя стійкості, витривалості, любові і краси.
Безмежно вдячні нашим героїчним Збройним Силам за кожен день, який наближає ПЕРЕМОГУ!
Вітаємо всіх жінок зі святом весни!
Бажаємо тиші, витримки і терпіння!
Ми б’ємо ворога і рухаємося до Перемоги!
Працюємо й донатимо на Перемогу!
Все завжди є й буде Україна!
Шановні колеги!
Зимова онлайн-школа
"Україна на шляху до євроатлантичної спільноти"
15-17 лютого 2023 р.
Реєстрація для участі:
натисніть для реєстрації
Міжнародний форум
«Модернізація педагогічної освіти у глобальному вимірі безпеки соціально-турбулентного світу»
у змішаному режимі (он-лайн і оф-лайн)
16 лютого 2023 року
ВЕБІНАР
07.02.23 р. відбувся вебінар
«Зміни в базових документах розроблення професійних стандартів»,
який проводила Федерація роботодавців спільно з Національним агентством кваліфікацій.
Під час вебінару були представлені зміни у національній кваліфікації професій, роз’яснено правила проходження навчання для написання стандартів кваліфікацій.
ВЕБІНАР
Шановні колеги, доброго дня!
Федерація роботодавців України спільно з Національним Агентством кваліфікацій запрошує 07.02.2023р. об 11.00 на вебінар за темою:
«Зміни в базових документах розроблення професійних стандартів»
Реєестрація за посиланням:
https://docs.google.com/forms/d/e/1FAIpQLSchYhk-zARUV5_HsXRbev94CebP_vVNlU-URlRo7WoZEIi5kQ/viewform
Семінари для гарантів освітніх програм УДУ імені Михайла Драгоманова
З 30.01.2023 по 02.02.2023 року
відділ ліцензування та акредитації спільно з Центром моніторингу якості освіти, організаційно-методичним управлінням НМЦ та відділом аспірантури і докторантури проводить семінари для гарантів щодо підготовки до акредитації освітніх програм в умовах воєнного стану
Формат зустрічей змішаний
Матеріали для підготовки до акредитації освітніх програм будуть доступні на курсі у мудлі
Форма для реєстрації на семінари https://cutt.ly/e9nIJGZ
Конкурси на отримання грантів UNESCO/PhosAgro/IUPAC
Національний фонд досліджень України оголосив новий конкурс проєктів «Наука для відбудови України у воєнний та повоєнний періоди»!
Метою конкурсу є фінансування колективних наукових проєктів, спрямованих на вирішення невідкладних питань відбудови України у воєнний та повоєнний періоди
Термін подання заявок: з 23 грудня 2022, 00:01 по 31 січня 2023, 23:59 (за київським часом).
Національний фонд досліджень України оголошує новий конкурс “Кембридж – НФДУ 2023!
Метою конкурсу є підтримка передових наукових досліджень і розробок українських вчених, які безпосередньо постраждали від воєнних дій в Україні в 2022 році, шляхом надання індивідуальних грантів за підтримки Кембриджського університету (Велика Британія)
Термін подання заявок: з 23 грудня 2022, 00:01 по 27 січня 2023, 23:59 (за київським часом).
Науково-педагогічне стажування
ISMA University of Applied Sciences
Науково-педагогічне стажування з природничих наук
ОСОБЛИВІ МЕТОДИ ОРГАНІЗАЦІЇ ОСВІТНЬОГО ПРОЦЕСУ ДЛЯ ЗДОБУВАЧІВ ОСВІТИ У ГАЛУЗІ БІОЛОГІЇ, ЕКОЛОГІЇ, ГЕОГРАФІЇ, ГЕОЛОГІЇ ТА ХІМІЇ
м. Рига, Латвійська Республіка
19 грудня – 29 січня 2023 року
Навчальне навантаження стажування становить 6 кредитів ЄКТС (180 годин).
Форма участі: дистанційна. Переглянути на сайті >
Науково-педагогічне стажування
Науково-педагогічне стажування з педагогічних та психологічних наук
«Проблеми та стратегії розвитку педагогічної
та психологічної освіти в Україні та країнах ЄС»
м. Рига, Латвійська Республіка
19 грудня – 29 січня 2023 року
Навчальне навантаження стажування становить 6 кредитів ЄКТС (180 годин).
Форма участі: дистанційна
ВІТАННЯ ВІД ДЕКАНА ФАКУЛЬТЕТУ
Шановні студенти та колеги!
Минає цей найважчий та найстрашніший рік. Підводячи підсумки, можна сказати, що Україна і ми з вами достойно пройшли його випробовування. У наступному 2023 році хочу побажати нам почути найсолодше для нас слово - ПЕРЕМОГА!!!
Хай наступний рік принесе нам мир і спокій, збереже життя і здоров´я наших воїнів, хай Господь пригорне усіх українців до себе і захистить від зла. Хай у наступному році почне розпадатись росія і планета Земля, нарешті, почне вільно дихати.
Щастя і здоров´я усім вам і вашим рідним!
З НОВИМ РОКОМ!!!
Ваш декан Ганна Турчинова
З РІЗДВОМ!
Шановні колеги, студенти, батьки!
Від щирого серця вітаю вас із найсвітлішим святом нашої цивілізації - Різдвом Христовим. Свято Різдва Христова - найбільший подарунок від Бога! Саме від цього народження ми ведемо літочислення нашої ери. Саме Христос приніс у світ десять заповідей моралі і навчив людей бути щирими, чесними, справедливими, добросердечними та порядними. Навчив людей любити і бути милосердними.
Хай цьогорічне Різдво принесе нашій краіні Перемогу, знищить зло, а доля більше не буде випробовувати нас на міцність! Хай Господня сила та опіка будуть завжди поряд, зміцнюють нашу віру, розтоплюють наші серця та дають нам впевненість робити успішні кроки.
Хай Господь убереже наших воїнів та втішить серця тих, хто втратив найрідніших. Перемоги нам скорішої, миру та спокою.
ІЗ СВЯТОМ РІЗДВА !
Декан факультету, Турчинова Ганна Володимирівна
ВІТАННЯ ВІД СТУДЕНТІВ ФАКУЛЬТЕТУ
ВІТАННЯ ВІД ЦЕНТРУ ДААД
Співробітники Центру ДААД вітають наш факультет із новим 2023 роком і бажають здоров'я та миру!
Alles Gute für 2023
Ein herausforderndes Jahr geprägt von Pandemie, Krieg und weltweiten Unruhen neigt sich dem Ende zu. Gerade in diesen Zeiten sind Vertrauen, Beständigkeit und Zuversicht besonders wertvoll.
Wir bedanken uns ganz herzlich bei Ihnen für das entgegengebrachte Vertrauen in diesem Jahr, die beständige und konstruktive Zusammenarbeit.
Zuversichtlich blicken wir dem kommenden Jahr entgegen und freuen uns auf neue gemeinsame Aufgaben und Projekte.
Ein glückliches, gesundes und friedvolles Jahr 2023
wünschen Ihnen die Mitarbeiterinnen und Mitarbeiter
von g.a.s.t.
